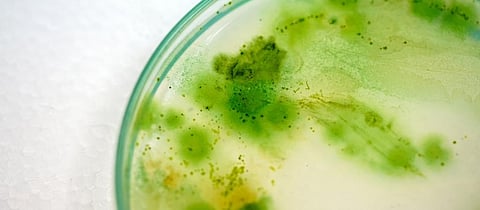
Gene that can boost photosynthesis identified in cyanobacteria

Scientists from the Michigan State University (MSU) have identified a set of genes in cyanobacteria — also called as blue-green algae — that can help boost energy yield from photosynthesis, and also pave way for a sustainable biotech production.
Cyanobacteria species are both aquatic and photosynthetic, meaning they live in water and can make their own food.
The bacterial species share with plants an enzyme called rubisco, which plays a key role in photosynthesis — it captures carbon dioxide (CO2) from the atmosphere and converts carbon into high-energy molecules.
The process known as carbon dioxide fixation can help boost photosynthesis rates in plants, increase yield as well as lower carbon dioxide emissions. However, often small molecules in plants block the enzyme. Rubisco activase, the protein, removes the unwanted molecules from plants and helps rubisco to continue the food making process.
The team from MSU’s Cheryl Kerfeld lab identified a cyanobacterial gene, called Activase-Like Cyanobacterial protein, or ALC, that is similar to the plant rubisco activase.
“This gene is widespread in many taxonomic groups of cyanobacteria. Those include various unicellular and multi-cellular, filamentous species,” said Sigal Lechno-Yossef, research assistant professor in the Kerfeld lab. The research is published in the journal New Phytologist.
The researchers combined ALC from a model cyanobacterium, Fremyella diplosiphon, with rubisco enzyme from the same organism, in a test tube.
The ALC did not help rubisco in removing the small molecules. But, in the cell, the protein was found physically similar to the plant rubisco.
“We also have bioinformatic evidence that shows ALC evolving along with rubisco in cyanobacteria. This finding is further support for interaction between these two proteins,” Lechno-Yossef said.
While ALC does not unblock rubisco, it helps, rubisco proteins to aggregate, Lechno-Yossef said.
“This function is similar to that of another cyanobacterial protein, which is known to contribute to rubisco regulation and localisation in the cell,” Lechno-Yossef added.
Besides, ALC also aids in photosynthesis by helping its host to detect CO2 levels.
When the ALC gene was deleted in Fremyella diplosiphon, it did not experience dramatic changes in their growth, a stark difference compared to plants. Deleting the rubisco activase in plants can starve them of carbon, the researchera noted.
“However, those same strains experienced morphological changes when grown in CO2-rich environments,” found the study.
The findings can help efforts to improve rubisco that will “increase energy yield from photosynthesis”, Lechno-Yossef said.
“The goal would be to rewire cyanobacteria’s photosynthetic machine to produce renewable energy compounds or materials for use in medicine or industry,” Lechno-Yossef said.
“Now we know that cyanobacteria have an enzyme that supports rubisco, we could try making more robust cyanobacteria for industrial applications,” said Lechno-Yossef.